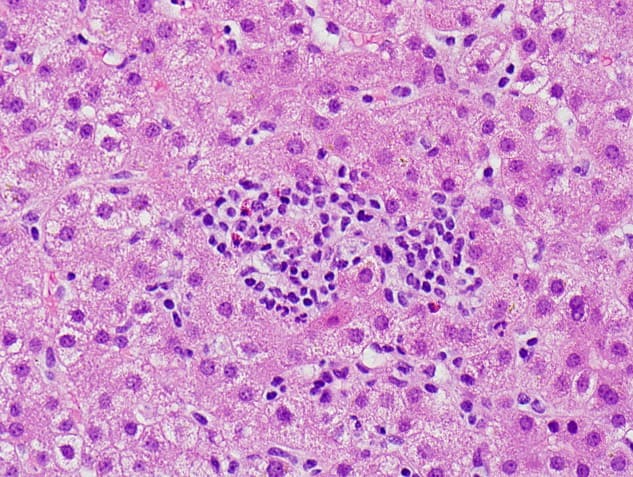
نکروز

مقدمهای بر پارامترهای قابل اندازه گیری فلوسایتومتری
این واقعیت که فلوسایتومتری امکان اندازه گیری همزمان چند پارامتر سلولی را فراهم میکند یکی از قدرتمندترین جنبه های این فناوری است. این تکنیک طیف وسیعی از کاربردها از جمله شناسایی آنتی ژن ها در داخل یا روی سطح سلول، تجزیه و تحلیل DNA و RNA و تعدادی کاربرد بالقوه دیگر را دارد. چند نمونه از پارامترهایی که میتوان با استفاده از فلوسایتومتری ارزیابی کرد در زیر توضیح داده شده است.
تجزیه و تحلیل عملکرد
فلوسایتومتری را میتوان برای ارزیابی تغییراتی که در یک دوره زمانی کوتاه در سلولها رخ میدهد استفاده کرد. فعالیتهای بیولوژیکی مانند تغییر در محتوای کلسیم در پاسخ به داروها. تولید گونههای فعال اکسیژن یا تغییرات غشای میتوکندری در طول آپوپتوز و نرخ فاگوسیتوز با استفاده از باکتریهای برچسبگذاری شده، همگی با استفاده از فلوسیتومتری قابل ارزیابی هستند.
قابلیت زنده ماندن
یک رنگ پیوند دهنده DNA را می توان به جمعیت سلولی اضافه کرد تا بقای سلول را پس از معرفی یک ارگانیسم بیماری زا ارزیابی کند. هنگامی که یکپارچگی غشای پلاسمایی به خطر می افتد، یک سلول نکروزه می شود و اجازه می دهد رنگ های زنده به آن وارد شوند. سلولهای مرده را میتوان در مراحل اولیه یا پایانی نکروز با استفاده از طیف وسیعی از رنگهای زنده، تعیین کمیت DNA و از طریق اندازهگیری پراکندگی جانبی پروب غشایی Bis-oxonal شناسایی کرد.
آپوپتوز
به خود تخریبی یک سلول طبق دستور ژن ها آپوپتوز گفته میشود. فلوسایتومتری را میتوان برای تشخیص تغییرات مورفولوژیکی و بیوشیمیایی مشخص که در طول آپوپتوز رخ میدهد استفاده کرد.

نمونههایی از تغییرات مورفولوژیکی عبارتند از: تغییر در شکل سلول، از دست دادن ساختار روی سطح سلول، جدا شدن سلول، تراکم سیتوپلاسم، انقباض سلولی، فاگوسیتوز باقیماندههای سلولی و تغییر در پوشش هسته. برخی از نمونههای تغییرات بیوشیمیایی شامل پروتئولیز، دناتورهسازی DNA، کم آبی سلولی، اتصال متقابل پروتئین و افزایش یونهای کلسیم آزاد است.
نکروز
اندازه گیری نکروز را می توان از فرآیندهای انکوز، آپوپتوز و خود فاگوسیتوز به دست آورد. انکوز به نکروز به عنوان نتیجه رویدادی اشاره دارد که باعث تورم سلول به جای کوچک شدن میشود (همانطور که در آپوپتوز رخ میدهد).
در طی آنکوز، سلول و اندامک های داخل آن متورم میشوند. غشای پلاسمایی در نهایت پاره میشود و به دنبال آن مرحله نکروز رخ میدهد که در آن سلول آنزیم های پروتئولیتیک را آزاد میکند که به بافت اطراف آسیب میزند. سلول کوچک میشود (آپوپتوز) و تغییراتی در ساختار میتوکندری و پتانسیل گذرنده رخ میدهد. کروماتین نیز متراکم میشود.
تجزیه و تحلیل چرخه سلولی
تکثیر سلولی را میتوان با اندازه گیری مراحل مختلف چرخه سلولی در جمعیتی از سلول ها ارزیابی کرد. محتوای DNA در هر مرحله از چرخه سلولی متفاوت است و این را میتوان با استفاده از رنگ های فلورسنت اتصال DNA و آنتی بادی های مونوکلونال بیان آنتی ژن ها را ارزیابی کرد.

از آنجایی که هیستون H3 تحت فسفوریلاسیون بین پروفاز و آنافاز قرار میگیرد، این پروتئین میتواند برای تمایز بین فازهای G2 و m هنگام ارزیابی چرخه سلولی مورد استفاده قرار گیرد.
برخی از نمونه های دیگر از پارامترهایی که میتوان با استفاده از فلوسایتومتری ارزیابی کرد در زیر فهرست شده است:
- اندازه گیری رنگدانه های سلولی مانند کلروفیل یا فیکواریترین
- اندازه گیری تنوع تعداد کپی DNA با استفاده از Flow-FISH (هیبریداسیون درجا فلورسنت) یا فناوری BACs-on-Beads
- اندازه گیری آنتی ژن های داخل سلولی مانند سایتوکینها یا واسطههای ثانویه
- اندازه گیری فعالیت آنزیمی
- اندازه گیری انفجار اکسیداتیو
- تشخیص گلوتاتیون
- اندازه گیری چسبندگی سلولی
همچنین بخوانید:
- فلوسایتومتری چند رنگ چیست؟
- ایمونوفنوتایپینگ در فلوسایتومتری
- دوره مهارت آموزی فلوسایتومتری
- فلوسایتومتری برای شناسایی اهداف واکسن برای SARS-CoV-2
- فلوسایتومتری تصویربرداری میکروسیال
- فلوسایتومتری در سنجش عملکرد پلاکت در نوزادان



